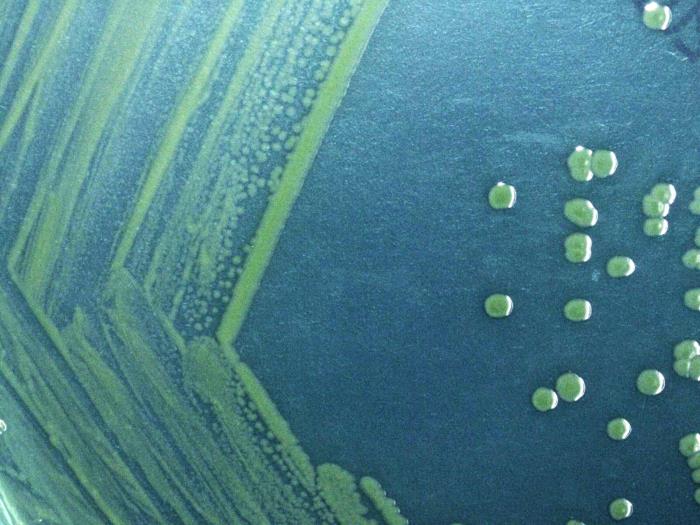
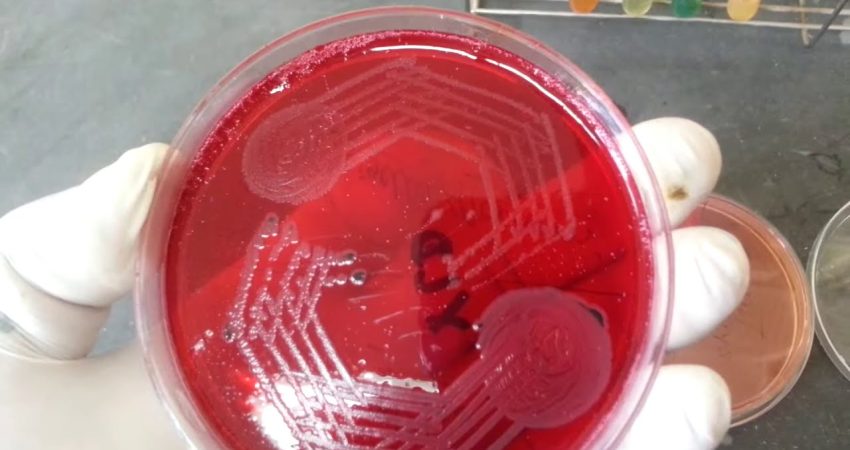

Një tjetër sëmundje viral po bëhet rezistente ndal antibiotikëve. Ekspertët e shëndetësorë në Britani kanë lëshuar një udhëzim se shigella sonnei, një sëmundje infektive që kryesisht prek meshkujt homoseksualë dhe biseksualë po bëhet më rezistente. Agjencia e Sigurisë Shëndetësore në Mbretërinë e Bashkuar (UKHSA) tha se kjo është vënë re edhe nga rritja e rasteve me këtë infeksion.
Rreth 47 raste u raportuan në periudhën katër mujore midis shtatorit 2021 dhe janarit 2022, krahasuar me vetëm 16 raste në 17 muajt e mëparshëm (prill 2020 deri në gusht 2021).
UKHSA tha se ka ndjekur llojin, i cili shpesh mund të ngatërrohet me helmim nga ushqimi, që nga viti 2018 “por ajo çfarë mbetet shqetësuese është se rezistenca e antibiotikëve është në rritje.
Kjo e fundit është një gjendje që ndodh kur mikrobet si bakteret dhe kërpudhat zhvillojnë aftësinë për të mposhtur ilaçet e përdorura për trajtimin e tyre. Kjo do të thotë se bakteret nuk vriten dhe vazhdojnë të rriten. Shigella është një infeksion i zorrëve që shkakton diarre (ndonjëherë të përzier me gjak), dhimbje në stomak dhe ethe. Shkaktohet nga bakteret që gjenden në feçe dhe për këtë arsye mund të përhapet përmes marrëdhënieve seksuale.
“Ajo transmetohet përmes rrugës fekalo-orale gjatë seksit, qoftë drejtpërdrejt ose nëpërmjet duarve të palara, dhe vetëm një sasi e vogël bakteresh mund të përhapë infeksionin,” kanë shkruar ekspertët e UKHSA.
Simptomat zakonisht shfaqen një deri në katër ditë pas marrjes së infeksionit dhe shpesh ngatërrohet me helmim nga ushqimi. Shumica e rasteve do të zhduken brenda një jave, por disa njerëz kanë nevojë për trajtim spitalor me antibiotikë intravenozë, megjithëse janë të kufizuar për shkak të rezistencës së tij ndaj antibiotikëve. Gauri Godbole, konsulent mikrobiolog mjekësor në UKHSA, tha se praktikimi i higjienës së mirë pas marrëdhënieve seksualë është vërtet i rëndësishëm për të qenë të sigurte.
“Shmangni seksin oral menjëherë pas seksit anal, ndërroni prezervativët midis seksit anal ose oral dhe lani duart me sapun pas kontaktit seksual. Është e rëndësishme që homoseksualët, biseksualët dhe jo vetëm, të mos i shpërfillin simptomat e tyre dhe të flasin me mjekun e tyre”, shton Godbole.
Eksperti shpjegon se nëse dikush është i diagnostikuar me shigella duhet t’i japi vetes kohë për t’u rikuperuar. Sipas mjekut duhet që personat e prekur nga ky infeksion duhet të qëndrojnë të hidratuar, të mos kryejnë marrëdhënie seksuale shtatë ditë pas simptomave dhe të shmangin notin dhe qëndrimin në spa, xhakuzi, apo të përdorin mjetet personale të të tjerëve.
Burimi: The Indipendent/ Përshtati:Gazeta “Si”
Copyright © Gazeta “Si”
Të gjitha të drejtat e këtij materiali janë pronë ekskluzive dhe e patjetërsueshme e Gazetës “Si”, sipas Ligjit Nr.35/2016 “Për të drejtat e autorit dhe të drejtat e tjera të lidhura me to”. Ndalohet kategorikisht kopjimi, publikimi, shpërndarja, tjetërsimi etj, pa autorizimin e Gazetës “Si”, në të kundërt çdo shkelës do mbajë përgjegjësi sipas nenit 179 të Ligjit 35/2016.
.png)

Lini një Përgjigje